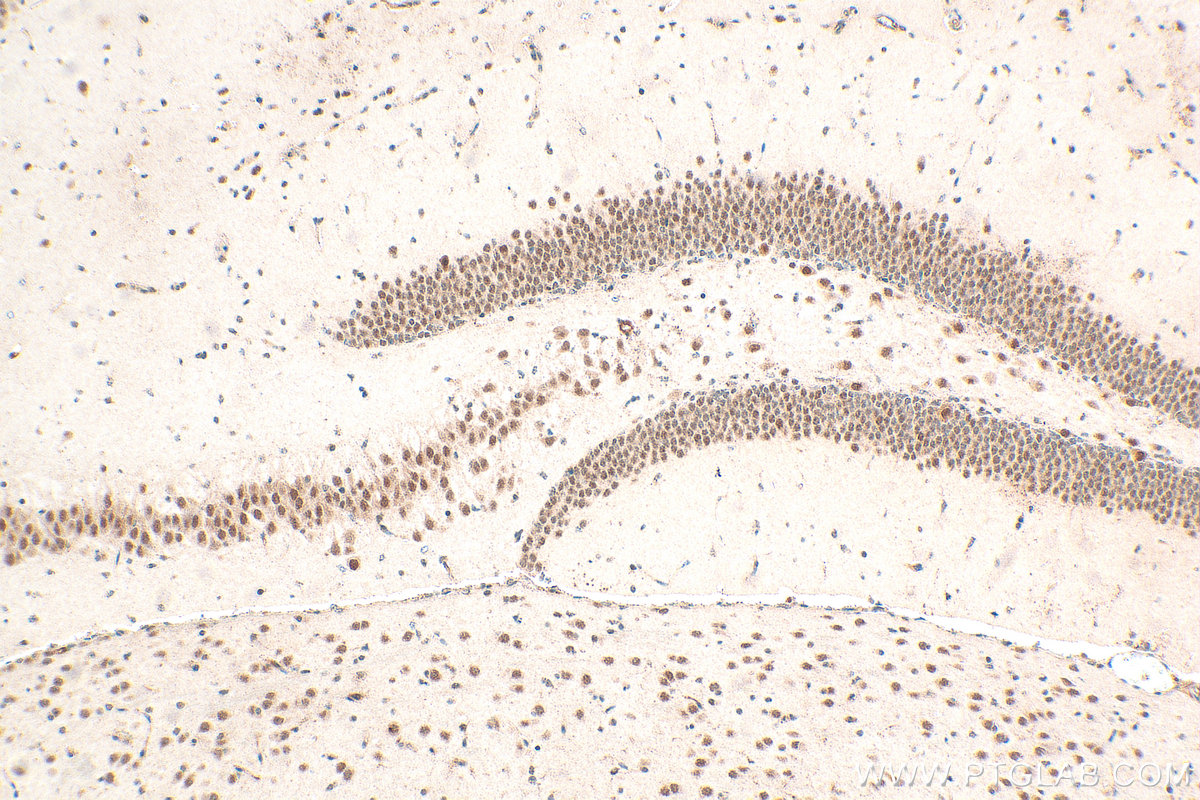
Immunohistochemical analysis of paraffin-embedded mouse brain tissue slide using 21952-1-AP (NCOA1/SRC-1 antibody) at dilution of 1:400 (under 10x lens). Heat mediated antigen retrieval with Tris-EDTA buffer (pH 9.0). IHC staining of mouse brain using 21952-1-AP

验证数据展示
经过测试的应用
| Positive WB detected in | Jurkat cells, Raji cells |
| Positive IHC detected in | mouse brain tissue Note: suggested antigen retrieval with TE buffer pH 9.0; (*) Alternatively, antigen retrieval may be performed with citrate buffer pH 6.0 |
推荐稀释比
| 应用 | 推荐稀释比 |
|---|---|
| Western Blot (WB) | WB : 1:2000-1:12000 |
| Immunohistochemistry (IHC) | IHC : 1:200-1:800 |
| It is recommended that this reagent should be titrated in each testing system to obtain optimal results. | |
| Sample-dependent, Check data in validation data gallery. | |
产品信息
21952-1-AP targets NCOA1/SRC-1 in WB, IHC, IF, CoIP, ELISA applications and shows reactivity with human, mouse samples.
| 经测试应用 | WB, IHC, ELISA Application Description |
| 文献引用应用 | WB, IF, CoIP |
| 经测试反应性 | human, mouse |
| 文献引用反应性 | human, rat |
| 免疫原 |
CatNo: Ag16603 Product name: Recombinant human NCOA1 protein Source: e coli.-derived, PGEX-4T Tag: GST Domain: 1122-1441 aa of BC111533 Sequence: RQRQLIQQQRAMLMRQQSFGNNLPPSSGLPVQMGNPRLPQGAPQQFPYPPNYGTNPGTPPASTSPFSQLAANPEASLANRNSMVSRGMTGNIGGQFGTGINPQMQQNVFQYPGAGMVPQGEANFAPSLSPGSSMVPMPIPPPQSSLLQQTPPASGYQSPDMKAWQQGAIGNNNVFSQAVQNQPTPAQPGVYNNMSITVSMAGGNTNVQNMNPMMAQMQMSSLQMPGMNTVCPEQINDPALRHTGLYCNQLSSTDLLKTEADGTQQVQQVQVFADVQCTVNLVGGDPYLNQPGPLGTQKPTSGPQTPQAQQKSLLQQLLTE 种属同源性预测 |
| 宿主/亚型 | Rabbit / IgG |
| 抗体类别 | Polyclonal |
| 产品类型 | Antibody |
| 全称 | nuclear receptor coactivator 1 |
| 别名 | NCOA1, SRC 1, bHLHe42, BHLHE74, Class E basic helix-loop-helix protein 74 |
| 计算分子量 | 1441 aa, 157 kDa |
| 观测分子量 | 140-160 kDa |
| GenBank蛋白编号 | BC111533 |
| 基因名称 | SRC 1/NCOA1 |
| Gene ID (NCBI) | 8648 |
| RRID | AB_2935455 |
| 偶联类型 | Unconjugated |
| 形式 | Liquid |
| 纯化方式 | Antigen Affinity purified |
| UNIPROT ID | Q15788 |
| 储存缓冲液 | PBS with 0.02% sodium azide and 50% glycerol, pH 7.3. |
| 储存条件 | Store at -20°C. Stable for one year after shipment. Aliquoting is unnecessary for -20oC storage. |
背景介绍
Nuclear receptor coactivator 1, also named SRC-1, directly binds nuclear receptors and stimulates transcriptional activities in a hormone-dependent fashion. Involved in the coactivation of different nuclear receptors, such as for steroids (PGR, GR, and ER), retinoids (RXRs), thyroid hormone (TRs), and prostanoids (PPARs). Also involved in coactivation mediated by STAT3, STAT5A, STAT5B, and STAT6 transcription factors. Displays histone acetyltransferase activity toward H3 and H4; the relevance of such activity remains however unclear. Plays a central role in creating multisubunit coactivator complexes that act via the remodeling of chromatin, and possibly act by participating in both chromatin remodeling and recruitment of general transcription factors. Required with NCOA2 to control energy balance between white and brown adipose tissues. Required for mediating steroid hormone response. Isoform 2 has a higher thyroid hormone-dependent transactivation activity than isoform 1 and isoform 3.
实验方案
| Product Specific Protocols | |
|---|---|
| IHC protocol for NCOA1/SRC-1 antibody 21952-1-AP | Download protocol |
| WB protocol for NCOA1/SRC-1 antibody 21952-1-AP | Download protocol |
| Standard Protocols | |
|---|---|
| Click here to view our Standard Protocols |
发表文章
| Species | Application | Title |
|---|---|---|
Phytother Res Oleanolic Acid Up-Regulated UGT1A1 and Antagonized Inflammation by Affecting the Binding of PXR and PKCα to HSP90α and SRC1 | ||
Oncogene Disruption of androgen receptor-cofactor interactions by the RNA-binding protein FUS/TLS alters androgen signalling in prostate cancer. | ||
Exp Cell Res EP300/NCOA1 complex drives glioma angiogenesis via H3K27 acetylation-dependent activation of VEGFA. |